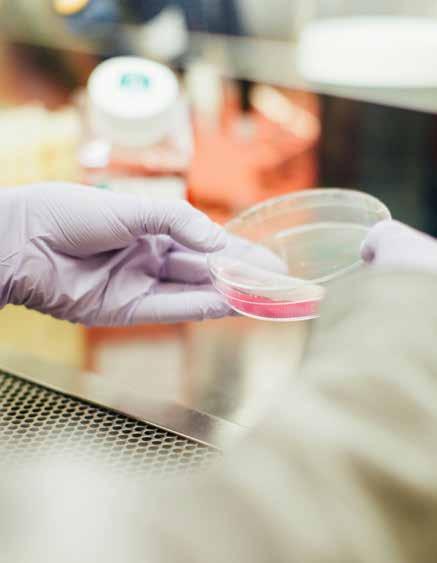

MILK PRODUCER MAGAZINE CELEBRATING 100 YEARS 19 25-2025
APRIL 2025 | THE VOICE OF ONTARIO DAIRY PRODUCERS

![]()
MILK PRODUCER MAGAZINE CELEBRATING 100 YEARS 19 25-2025
APRIL 2025 | THE VOICE OF ONTARIO DAIRY PRODUCERS




#5* West River Farm Ltd
Grant & Gene Sache and Families Rosedale, BC 182 Cows MilkingRobot



Faralary Hill Farms Ltd
Emily & Braden Bertens Steve & Teresa MacKay Embro, ON 104 Cows MilkingRobot

Opsterlawn Holsteins Ltd
Marten & Margriet Bylsma Alma, ON 344 Cows MilkingParlour
Congratulations to top herds who were recognized at the unveiling of Canada’s Best Managed Dairy Herds for 2024 and thank you to everyone who joined the celebration!
See the full list of Canada's Best Managed Dairy Herds at lactanet.ca
Watch the highlights of our celebration on YouTube
PUBLISHED BY
DAIRY FARMERS OF ONTARIO
6780 Campobello Road
Mississauga, ON L5N 2L8
MANAGER, COMMUNICATIONS
Sharon Laidlaw sharon.laidlaw@milk.org
ADVERTISING
Pat Logan pat.logan@milk.org 519-788-1559
GRAPHIC DESIGN
Katrina Teimo
CONTRIBUTORS
Robert Matson, Hanne Goetz, Catherine Arpin, Célia Julliot, Francois Gonothi Toure, Christine O’Reilly, Hannah Sweett, ACER Consulting, Émie Désilets, Annik L’Espérance, Chris McCullough Veal Farmers of Ontario,
Canada Post Publications Mail Sales Product Agreement No.40063866.
Return postage guaranteed. Circulation: 8,000. ISSN 0030-3038. Printed in Canada.
SUBSCRIPTIONS
For subscription changes or to unsubscribe, contact:
MILK PRODUCER
6780 Campobello Road
Mississauga, ON L5N 2L8
Phone: (905) 821-8970
Fax: (905) 821-3160
Email: milkproducer@milk.org
Opinions expressed herein are those of the author and/ or editor and do not necessarily reflect the opinion or policies of Dairy Farmers of Ontario. Publication of advertisements does not constitute endorsement or approval by Milk Producer or Dairy Farmers of Ontario of products or services advertised.
Milk Producer welcomes letters to the editor about magazine content.
*All marks owned by Dairy Farmers of Ontario.
WEBSITES & SOCIAL MEDIA
www.milkproducer.ca
www.milk.org
Facebook: /OntarioDairy
X: @OntarioDairy
Instagram: @OntarioDairy
LinkedIn: dairy-farmers-of-ontario



Highlighting how Living Lab - Ontario brings practical research to the dairy farm
UK sheep shearer excels at New Zealand share-milking


For more than 60 years, research has played a core role in the success and health of Ontario’s dairy industry, strengthening our farms, enabling sustainable growth and guiding our collective future. At Dairy Farmers of Ontario (DFO), we continue to prioritize sustainable production. This is reflected in our research into efficiency and sustainability through practical and applied research, as well as investment in long-term opportunities to continue to position our sector for growth through innovation and technology adoption.
One way we do this is with the practical research studies through Living Lab - Ontario. It’s not just a research initiative; it's based on the principles of co-development. Living Lab - Ontario involves a collaboration between various partners, including DFO. The project’s goals are diverse and includes increasing adoption of best management practices (BMPs) that sequester carbon and reduce greenhouse gas. Additionally, the collaboration across sectors enables us to focus on manure and soil management, emphasizing both environmental and economic benefits.
By participating in the Living Lab - Ontario project, dairy farmers can adopt BMPs that help reduce their carbon footprint and improve soil health and crop yields. And by testing these practices on-farm and evaluating them, dairy
farmers can gain actionable insights and implement BMPs that contribute to a more sustainable future. The project also fosters farmer-to-farmer learning opportunities, allowing dairy farmers to share knowledge and experiences, further enhancing the adoption of sustainable practices.
Another example of research that benefits us directly on the farm is through the Natural Sciences and Engineering Research Council of Canada (NSERC). For more than 25 years, the NSERC Industrial Research Chair in Dairy Cattle Welfare at the University of British Columbia (UBC) has shaped how dairy cattle are cared for in Canada and beyond. With long-standing support from Dairy Farmers of Canada, researchers Dr. Dan Weary and Dr. Nina von Keyserlingk have led globally recognized work that has improved animal welfare, productivity and public trust in the dairy industry. Canadian dairy farmers have always been leaders in animal care, and our industry research efforts reinforce this message.
Researchers are always striving to make our industry better by helping us put their re-search into practice on the farm. On my dairy operation, practical research solutions mean increased opportunities for efficiency, innovation and sustainability at the farm level. We’re currently putting an addition on our barn and are analyzing data to determine which


robots or milking parlour we’ll choose, including making decisions on stalls or pack barn, sand or mats. With a focus on cow comfort, we’re also researching different animal health and milk quality improvements and innovations. Our aim is to be at the forefront of cow comfort and health because we know a healthy farm starts with a healthy cow.
Researchers are essential collaborators in the dairy industry. They bring innovative ideas and investigative skills, but they also value input from producers to ensure their research remains relevant and delivers practical results back to the farms. This collaboration is crucial to help bridge the gap between scientific research and practical application, ensuring innovations are effectively implemented on farms to enhance efficiency, sustainability and overall productivity.
I encourage you to read through this issue and find out all the ways our industry is benefiting from our research dollars.
From ever-evolving regulations to dietary trends and global producers penetrating Canada’s dairy market, you face a myriad of challenges. Let MNP help you capitalize on new opportunities, streamline operations, and improve your bottom line.


By Hanne Goetz, PhD; Research Associate in the Department of Population Medicine at the University of Guelph
Over the four-year period from 2021 to 2024, Dairy at Guelph researchers received an average of $6.1 million per year in total funding for dairy research.
AT THE UNIVERSITY OF GUELPH, we are privileged to have the support of many dairy farmers who allow us to collect data for research projects. It is not uncommon to see a research car departing from the University of Guelph at 4 a.m. with a skilled team of researchers to collect data at multiple dairy farms. While some producers work with researchers on their own farms, all producers contribute through the five cents per hectolitre deduction from milk revenue that supports research projects. Either way, the projects they are participating in were likely conceived years earlier.
The researchers who collect data are also engaging in the dairy community and they take pride in building long-lasting relationships with producers and sharing the data collected on their farms. This is also a great opportunity for researchers with “boots on the ground” to learn about what research questions producers are interested in and what challenges they are facing. A key priority is addressing the industry’s current issues while strategically preparing for the challenges that could occur in the next five to 10 years. Although researchers bring their own ideas in need of investigation, they value the opportunity to gather ideas from producers, keep research connected to their needs and get practical results back to the farm.
Once a research topic is identified, the research team and partners build a plan to investigate it, including determining what samples and data will be needed, and from how many cows and farms to provide rigorous results. Researchers then seek competitive funding opportunities to get the research done. Universities and their partners, such as the Agriculture Research Institute of Ontario, provide infrastructure for some projects but the funding for research lies largely with the researcher. Many organizations, such as the federal Natural Sciences and Engineering Research Council, the Ontario Ministry of Agriculture, Food and Agribusiness, as well as nutrition, genetics, equipment or pharmaceutical companies, and commodity groups, such as Dairy Farmers of Ontario and Dairy Farmers of Canada, play supporting roles.
It is common to require co-funding from one or more other partners. The grant-writing and review process can be time-consuming – often taking months between submission and receiving feedback or a decision on the proposal. However, this allows independent, external dairy research experts and producers serving as reviewers to raise questions and provide feedback on the study design, feasibility of the project and opportunities for practical implementation on farm. Typically, less than half of proposals are funded, but some may be improved and be successful in the future.
The funding process is integral to the success of dairy research at the University of Guelph, and our researchers are grateful for the immense support we’ve received over the years. Over the four-year period from 2021 to 2024, Dairy at Guelph researchers received an average of $6.1 million per year in total funding for dairy research. These funds pay for graduate student stipends, technicians’ and summer students’ salaries, expenses for scientific analyses and university infrastructure. None are used for faculty salaries. This funding is one of the many factors that allows Dairy at Guelph to be one of the largest groups of dairy researchers at any institution in the world.
After funding is secured, a principal investigator – in the case of research initiatives at the University of Guelph, this is typically a faculty member – may recruit a research team and/or graduate students who will gain hands-on experience in leading the project. This student and their research team will spend from weeks to years collecting data, such as

milk, blood or feed samples, behavioural or economic data, monitoring cow health or fertility outcomes, or dairy product quality, depending on the research objectives and project scope. Following completion of data collection, there may be laboratory or genetic analysis. Then the data are compiled, statistically analyzed and considered for biological insights and potential impact on farm. These results are prepared for publication in academic journals, such as the Journal of Dairy Science, and shared at scientific conferences worldwide and at local producer meetings to engage with knowledge users, including other dairy researchers, veterinarians and producers. Researchers use an increasing array of summaries, videos, social media and podcasts to get research results to farmers in ways they find useful. Dissemination of results is imperative to ensure new discoveries can be implemented on farm. Discussing research with a variety of stakeholders can lead to the next new idea. With every research project there are limitations, factors that could not be controlled in the study, or new questions that arise, and so begins the research process again.



By Catherine Arpin and Célia Julliot from McGill University, and Francois Gonothi Toure, L'Université du Québec à Montréal
WELCOME TO THE CORCAN FARM, the latest addition to research facilities used by McGill University and Université du Québec à Montréal (UQAM) students, under the research and innovation chair in animal welfare and artificial intelligence (WELL-E), to conduct research aimed at enhancing dairy cattle welfare and longevity in Canada. This farm is located in Kingston, Ont., and consists of a bedded-pack barn with a parallel milking parlour, differing from the tiestall farm at the McGill Macdonald campus. This new barn provides an opportunity to study dairy cows in a different environment


and represents a pilot farm where developed technologies can be tested for later application on a larger scale on commercial farms.
One of the most innovative aspects of the CORCAN farm is the integration of advanced technologies for analysing dairy cow behaviour. Using a network of high-resolution surveillance cameras, researchers can collect continuous videos to study animal movements and interactions. To ensure confidentiality and compliance with current regulations, an automatic blurring process has been developed

to anonymise the videos before they are analysed.
Once the videos have been secured on encrypted hard drives, they are ready for processing. Tracking algorithms enables individual detection and identification of each cow by analyzing her movements and behaviour in the barn. In the future, predictive analysis based on artificial intelligence will be implemented with the help of analysis pipelines developed at the McGill farm. These applications will focus on recognizing behaviour and detecting signs of stress or disease. This technological deployment represents a key stage in improving herd management and monitoring in real time.






As the WELL-E chair advances, so does the research scope. The controlled environment of the experimental farm allows researchers from UQAM and McGill to refine tracking algorithms, optimize data processing pipelines and validate the practical use of surveillance systems in real farming conditions. This ensures innovations are scientifically sound and applicable to commercial contexts, which is a main objective of the WELL-E research chair.
Another contribution of the CORCAN farm is to link research and application by testing how these technologies can be integrated in day-to-day farm operations and on animals that are not housed in tiestalls. Understanding cow behaviour in open environments provides

cow
producers how these technologies can improve welfare and productivity. By working closely with farmers and researchers to co-develop procedures, the pilot farm is accelerating adoption of innovative solutions and cuttingedge monitoring and management strategies become accessible and beneficial.
The CORCAN farm is contributing to improve dairy cow welfare research by enabling realtime behavioural monitoring. High-resolution cameras and tracking algorithms offer precise information on movements and interactions, helping improve welfare assessments and herd management. By testing these technologies in freestall and tiestall facilities, researchers can compare housing systems and develop farming strategies for practical environments. For producers, this pilot farm links research and practice, making sure AI-driven monitoring tools are effective and scalable, and can in turn improve herd management, increase productivity and promote long-term sustainability. As a demonstration site, the CORCAN farm encourages collaboration and helps adoption of innovations to improve animal welfare on Canadian dairy farms.
Effective: Control flies before they mature and breed.
Safe: For humans and
Effective: Control flies before they mature and breed.
Natural: Unlike pesticides, no harmful side effects.
Safe: For humans and other animals. Deadly for flies.
Economical: Comparable or less cost than pesticides.
Natural: Unlike pesticides, no harmful side effects.
Economical: Comparable or less cost than pesticides.


Highlighting how Living Lab - Ontario brings practical research to the dairy farm
By Robert Matson, Production Research Manager, Dairy Farmers of Ontario
SUSTAINABLE PRODUCTION IS AT THE HEART OF WHO WE ARE AS DAIRY FARMERS OF ONTARIO. To realize Dairy Farmers of Canada's sector goal of reaching Net Zero by 2050 and achieve our ambitious sustainability targets, we can't just talk about solutions—we need to test them and see them in action. The Living Lab - Ontario isn't just an innovation initiative; it's based on the principles of co-development, where scientists work together with producers and industry experts to experiment and develop economically efficient and environmentally sustainable solutions.
The Ontario Soil and Crop Improvement Association (OSCIA), Beef Farmers of Ontario, Dairy Farmers of Ontario, Grain Farmers of Ontario, Ontario Federation of Agriculture, Ontario Pork, Ontario Sheep Farmers and several other partners have embarked on a collaboration for an Ontario-based Living Lab. The breadth and scope of the Living LabOntario project goals are diverse but can broadly be summarized into three main domains, as illustrated with lead scientists identified below.


Overall, these goals summarize the work of Living Lab - Ontario:
• Test and evaluate “best bet” BMPs across regions and commodity groups to provide “local” examples reflective of different systems and producers;
• Improve and refine practices, methods and systems to increase adoption;
• Determine economic costs and benefits of BMPs and social factors impacting implementation;
• Collect data to validate C sequestration and GHG reduction models/ decision-making tools;
• Support farmer-to-farmer knowledge exchange opportunities.
Living Lab - Ontario has reached the end of its second year, and this month's cover story aims to highlight the researchers and Ontario dairy producers who have contributed to this project.
The Harrop family dairy farm (Harrcroft Acres) and Dr. Claudia WagnerRiddle from the University of Guelph are collaborating to measure and improve the impact of fertilizer and manure management on GHGs.
Dairy producer Janet Harrop summarizes the main purpose behind the project by stating, “We really want to know what the net greenhouse gas emissions are from a dairy cropping system under beneficial management practices compared to regional averages, considering both carbon dioxide and nitrous oxide emissions.”
To answer this question, the experimental site was set up into four fields and instrumented in 2024. These fields are set to have the following crop rotation.
Emissions from these fields are currently being monitored 24/7 using various instruments (See sidebar May 2024-May 2028).
Use of certain inhibitors reduced emissions by 30 per cent, while having both silage yield increases and higher crop removal (in lbs N/acre).
— Dr. Claudia Wagner-Riddle


“The crop rotation outlined here is typical of those seen on dairy operations in Ontario and the stage of rotation has been designed to capture the importance of livestock nutrients in soil health and examine the application of different BMPs,” Harrop says.
Although researchers are still examining preliminary results, Dr. Claudia Wagner-Riddle highlights that “use of certain inhibitors reduced emissions by 30 per cent, while having both silage yield increases and higher crop removal (in lbs N/acre)”. These results highlight some of the ways sustainable practices can lead to additional co-benefits for producers. By improving and testing these practices and evaluating them on-farm, researchers and producers aim to mitigate some of the uncertainty associated with these solutions.
Looking forward to this year, Wagner-Riddle aims to continue measuring while examining additional BMPs for each crop along with the Harrop family and other partners.
In the summer of 2024, several Living Lab - Ontario Knowledge Translation and Transfer (KTT) events took place across the province. One of these events was a field site demonstration on the Harrop family dairy farm. The event allowed those interested to learn about the work the researchers and the Harrop family were conducting on their active dairy farm.
Keep an eye out for other events in the summer of 2025 as researchers and producers continue to generate results together.


2021 Emissions from dairy farms
(source: Dairy Farmers of Canada - Environmental Life Cycle Assessment of Canadian Milk)
LCA,
Methane emissions from liquid manure account for an estimated 20 to 30 per cent of milk’s carbon footprint. A project led by Andrew VanderZaag of Agriculture and Agri-Food Canada aims to address how these emissions can be mitigated as we continue toward net zero.
Dr. VanderZaag highlights methane emissions are highest in conditions that are “anerobic (absent of oxygen), have a neutral pH (measure of acid/ base balance), are at warmer temperatures (>15 degrees Celsius) and have little or no competition for the nutrients that are used by the methane producers.”
This activity includes several dairy producers from across Ontario who are quantifying manure storage conditions on working farms. One of these farms, Hamlane dairy farm, has methane emissions (CH4) measured using a variety of instruments on farm. This includes open-path methane laser measurements of concentration downwind of the manure tank, as well as depth, temperature and manure sampling.
The goal of the first year of data collection was to establish baseline data for the farm. Looking forward to 2025, the researchers and producers

will add an additive to the time of the year when the temperature is >15°C to determine if there is an opportunity for mitigation, as has been demonstrated in the laboratory.
In lab results, lowering the pH from 6.9 to 6.7 with the help of sulphuric acid reduced methane emissions by 29 per cent. Further lowering the pH from 6.9 to 6.3 decreased it by 90 per cent when tested in the laboratory at 23°C. Although this result has been achieved in the laboratory, this activity will see if these results are applicable to commercial dairy farms in real climate.
The project includes several dairy producers from across Ontario who are quantifying conditions on their own farms. One of these farms, Hamlane dairy farm, is measuring methane emissions (CH4) using a variety of instruments.


Researchers have also expanded the activity to map emissions on farms. Using truck-mounted sensors, methane maps can be constructed to determine areas on the farm where methane emissions may be the most elevated. This technology is intended to be used in the future to examine the effect of covered manure storage, crust-covered sources, the effect of tank filling and other variables on methane concentration in the area surrounding manure storage.
An essential part of this initiative is connecting how the information is further utilized in modeling emissions on the farm. Data from these projects and from many of the Living Laboratories across Canada are being included in various modelling initiatives.
These modelling projects will provide actionable insights for farmers, so they can evaluate their own emissions on-farm and implement BMPs that contribute to a more sustainable future.
A significant component of the living lab program is the opportunity for producers, researchers and other industry stakeholders to engage in a process known as co-development. The research partners in this project are representative of the livestock industry and also include those from both provincial and federal government. These individuals are working together to make Living Lab - Ontario a success.

rest time means improved feed-to-milk conversion with Huber Technik 4GS Rubber Mattresses.
Co-development is the foundation for the innovation cycle in all 14 living labs across Canada. By identifying industry needs and outcomes, then testing and evaluating those solutions, we can continue to drive innovation that supports sustainable action.
Working together as an agriculture sector, the Living Lab - Ontario provides an opportunity for the dairy industry to support a more sustainable future.

An
essential part of this initiative is connecting how the information is further utilized in modeling emissions on the farm. Data from these projects and from many of the Living Laboratories across Canada are being included in various modelling initiatives.

FUTURE PERFORMANCE IS: PRECISION FEEDING WITH MAPLEVIEW PRECISION START
Mapleview Precision Start milk replacer is designed to provide stage-specific nutrition for the first three weeks of life, during the critical period when calves require energy, protein and a nutrient-dense formulation to support early growth, immune function, and digestive development
Mapleview Precision Start + Deccox (26-22-24) sets the foundation for higher production and long-term health.

By Christine O’Reilly, Forage and Grazing Specialist, Ontario Ministry of Agriculture, Food and Agribusiness

THE MOST COMMON CHALLENGE I HEAR from dairy farmers grazing lactating cows is they struggle to maintain milk components from pasture. Rather than bringing the herd back into the barn, the solution is to adjust the pasture management to set the cows up for success. These management tips are simple, but they are not always easy to do.
Digestible fibre drives milk components. Pasture plants are most digestible in their vegetative growth stages. When pasture plants head out, their stems lignify. Lignin is indigestible fibre. All grasses will put out a seed head at least once a year and they do so sometime before the summer solstice in late June. The goal as a pasture manager is to maximize the amount of time the pasture spends in a leafy, highly digestible state.
Stocking density is a key tool in maintaining highly digestible pastures. By giving the herd access to less space at a time, each cow becomes less selective about which plants she will eat. Start with high stocking densities in the spring, when the pasture is naturally highly digestible, to encourage cows to graze more evenly. This is important because any ungrazed plant will continue its development uninterrupted. The plants will be more mature than the grazed plants at the next grazing event, and their quality will be lower. The Noble Research Institute suggests cattle become non-selective in their grazing at stocking densities over 100,000 pounds of live weight per acre, but reductions in selectivity begin to occur at stocking densities as low as 10,000 lbs. per acre. Give the herd no more pasture than they can eat in 24 hours; better yet, allocate enough forage to get them between milkings, and give them a fresh strip to return to after being milked. Not only does this maintain high quality forage, it also improves cow flow.
Occasionally, farmers will tell me they prefer to give their cows lots of space (a low stocking density) and let them pick through to find the best quality forage. While cows are certainly good at finding the best feed in a field, this dramatically changes how they spend their time. Instead of eating and ruminating, they are searching and sorting, which can negatively impact milk production. Where supplemental feed is provided in the barn, milk per cow might not look very different, but milk per acre is much lower, and the cost to produce that milk is higher. No one expects a dairy cow to work for her feed in the barn, so don’t push her to do it on the pasture.
High stocking densities will not prevent pasture plants from heading out. Mowing the pasture after heading will encourage grasses to produce more leafy growth and reset the pasture quality. Mowing can also conserve high-quality forage to be fed in the non-grazing season.
Spring grass growth rates in Ontario can reach 200 kilograms of dry matter per hectare per day (180 lbs/acre/day). Spring growth rates easily outpace herd demands, so maintaining quality through grazing alone can be nearly impossible. Putting up surplus spring pasture as baleage, haylage or dry hay keeps pasture quality up and boosts forage inventories.
Species selection can make a big difference in how easy or difficult it is to keep pastures in a vegetative state. Some grass species will go through stem elongation and send up a seed head after each cutting or grazing event. Other species tend to only head out once and then grow leaves for the rest of the year. Grasses in this second category are easiest to manage as high-quality pasture. Orchard grass, tall fescue, meadow fescue, Kentucky bluegrass and perennial rye grass are all commonly grown pasture grasses that tend to only head out once per year.
Pasture palatability also influences milk production. If the pasture is not palatable, such as something off about the smell, texture or taste, the cows won’t eat as much if they don’t like it. It is difficult for managers to assess palatability without relying on cow behaviour and intake since cows experience pasture differently than humans do. Texture is the easiest aspect for us to make some judgements. Grab a handful of grass, but instead of ripping it off, let your hand slide up along the blades of grass. Smooth, soft grass is likely palatable. Some grasses, like older tall fescue varieties, are coarse and rough, and may even leave grass cuts on your
Pasture palatability also influences milk production. If the pasture is not palatable, such as something off about the smell, texture or taste, the cows won’t eat as much if they don’t like it.
hand. These are not palatable. Work with your seed supplier to choose varieties that are known to have soft leaves. Bonus points if they have data suggesting specific varieties were considered highly palatable by dairy cows.
While not enough digestible fibre from June onward is the most common problem, having too much digestible fibre on pasture can be a challenge at certain times of the year. Just like in the barn, keep an eye on manure consistency to gauge whether cows are getting the right amount of fibre and protein. Since pastures are constantly growing and changing, counting cud chews is a practice worth reviving to assess whether the cows are working too hard to make milk from pasture. Ideally, 60 to 80 chews per cud shows the cows are getting enough fibre without working too hard.
Keeping pastures leafy, green and vegetative will help drive milk components. Using a high stocking density, mowing strategically and considering the forage species and varieties seeded in the pasture all contribute to the forage quality cows need to make milk off grass.

*When used according to the label. 90816 Eprecis ad


Safe to use during all stages of lactation with no milk withdrawal*

EPRECIS® controls and treats a range of internal and external parasites, which can prevent skin lesions associated with ectoparasites.
Ask your veterinarian why Eprecis® could be right for your animals.

By Hannah Sweett - Knowledge Transfer Specialist – Genetics Portfolio, Lactanet
LACTANET HAS RECENTLY INTRODUCED A NEW WEBSITE for genetic tools at LactanetGen.ca. Those keen on querying genetic data can now find the well-known animal query, group query and inbreeding calculator tools, as well as the recently added beef-on-dairy query. Designed with users in mind, the website offers a seamless experience whether you’re using a desktop computer, tablet or mobile device, mirroring the familiar interface of cdn.ca but with updated technology and new features.
How do I find LactanetGen.ca?
1. Type LactanetGen.ca into your preferred browser;
2. By clicking on the “Genetic Tools” button located next to “MySite” in the Lactanet.ca header;
3. By navigating to the “Genetics” dropdown menu on Lactanet.ca and selecting "Genetic Tools - Animal Queries & Inbreeding Calculator."
What tools are available on LactanetGen.ca?
Use the homepage or “Menu” in the top right corner to navigate from any page to the animal query, group query, inbreeding calculator or beefon-dairy query tools. The animal query can be used to search animals by name, registration number, semen code or animal tattoo. Entering your herd prefix when searching by name will provide a list of all your registered animals. The group query can be used to query and filter top males and females for your breed of interest. Alternatively, the advanced search options will return more specific query results, including animals that are free or carriers of undesirable genetic conditions or haplotypes. The inbreeding calculator allows you to view pedigree inbreeding levels and parent averages for potential progeny from various matings. With LactanetGen.ca, these tools now have an improved design with minimal scrolling, allowing you to view an animal’s information at a quick glance.
Looking for more information on these tools? Check out the series of tips and tricks articles available on Lactanet.ca
What is the new beef-on-dairy query?
In response to the growing trend in the use of beef sire semen on dairy farms, Lactanet recently collaborated with Angus Genetics Inc. (AGI) and the Canadian Angus Association to introduce a new beef-on-dairy query tool to LactanetGen.ca. Using this query, you can perform a search on Canadian and American Angus bulls by name and narrow the search by those with semen actively marketed in Canada. A total of 11 traits of interest
to dairy farmers when breeding beef-on-dairy and two economic indexes, Angus-On-Holstein ($AxH) and Angus-On-Jersey ($AxJ), are provided for each bull. Under the “Evaluation Units” option, you may display the 11 traits in terms of either “Estimated RBV” or “GE-EPD” values.
The default display of Estimated RBV, will provide traits in a consistent pre-defined scale just like the dairy cattle genetic evaluations for functional traits. As with functional traits, the Estimated RBV values for the 11 Angus traits will have an average of 100 and a standard deviation of five. Values greater than 100 are always favourable. Using Estimated RBV allows you to compare values for multiple traits using the same scale and easily identify elite Angus sires that stand out for each trait. Alternatively, electing to display evaluations by GE-EPD or genomic enhanced expected progeny differences will display each trait according to the original scale of expression published by AGI. Once you have identified a sire of interest, look at the corresponding NAAB marketing code to identify which A.I. company to contact.
The ability to sign in to LactanetGen.ca provides you with the opportunity to customize your viewing experience. Simply navigate to the top right corner “Menu” and select “Sign In.” Upon successfully registering for an account and signing in, use the preferences page to select your primary breed for queries, your preferred selection index for default sorting and modify the display of an animal’s genetic evaluation summary page. For example, do you wish to view descriptive type traits by default rather than selecting the dropdown or to display intermediate optimum type traits by scorecard section? Simply select “Yes” and click “Save” before navigating to a query page to see the change.

The implementation of the modernized Lifetime Performance Index (LPI) on April 1, 2025 also brought with it additional customization abilities to the preferences page. Create a personalized LPI (pLPI) by modifying the percentage relative emphasis on each sub-index for your breed(s) of interest. Your pLPI will then be viewable on query pages beside the official LPI for each animal, allowing you to make individual breeding decisions that align with your goals.
Enrolled on DHI? Extra personalization features are available including the option to query by your DHI herd number to obtain a list of active animals in your DHI herd inventory. Make sure to provide your DHI herd number upon registering for an account or by clicking on “Manage Profile.”
1. The refinement filter feature of the group query tool, which provides the option to filter the resulting list of animals, now clearly shows which filters you have in place. After submitting a filter, the specific requirements will appear in the top grey bar before the list of animals. In the example below, a refinement filter has been selected for animals with an LPI greater than or equal to 3400 and a herd life evaluation greater than or equal to 105.

2. On a mobile device, a full overview of an animal’s genetic evaluation summary page is viewable without scrolling, providing the ability to quickly glance at the histograms or take screenshots;
3. A pop-up window containing carrier probability values for the undesirable genetic conditions and haplotypes known in each breed is available on each animal’s genetic evaluation summary, inbreeding calculator and pedigree pages. Hover over the blue circle with three dots beside the list of genetic condition codes below the animal’s name;

4. To also help manage the spread of known undesirable genes, a “GC” column for “Genetic Conditions” was added to the inbreeding calculator. For the selected mating animal, this column contains the genetic conditions for which they have a carrier probability of 25 per cent or higher. For the list of potential mates, this column will either appear blank, show a stop sign or warning sign to reflect the
In response to the growing trend in the use of beef sire semen on dairy farms, Lactanet recently collaborated with Angus Genetics Inc. (AGI) and the Canadian Angus Association to introduce a new beef-on-dairy query tool to LactanetGen.ca.
probability that the resulting pregnancy or calf will be affected by at least one of the undesirable conditions or haplotypes. For more information on the pop-up window and inbreeding calculator, read the “New Lactanet Tools to Manage Undesirable Genes” article on Lactanet.ca.
5. Originally introduced to the Lactanet website in 2021, the Genomics impact page is also available on LactanetGen.ca. This tool provides a visual representation of the impact genomic testing had on a trait-by-trait basis for each genotyped, Canadian female and the associated gain in reliability. Once a heifer is genotyped and the results are processed, the “Genomics Impact” tab will appear next to the “Summary” tab via the animal query.
Moving forward, LactanetGen.ca will be the only website for accessing updated Canadian genetics content. Make sure to update your favourite bookmarks and keep an eye out for new developments and enhancements, such as more customization abilities.





Participate in a research study that aims to understand how dairy farmers navigate their daily challenges and make decisions that impact their work and community life.
Take a 30 minute anonymous online survey
Skip questions you don’t want to answer
Receive $20 and a chance to win one of several $100 prizes
By Robert Matson, Production Research Manager, Dairy Farmers of Ontario
SUCCESS IN LIFE IS ALL ABOUT BUILDING THE RIGHT TEAM and working toward a lifelong mission of continuous improvement. Whether it is their veterinarian, a feed consultant, a certified crop adviser, a researcher or another professional, producers rely on the advice they receive to make informed decisions for their farm.
Conferences provide a perfect opportunity for producers, researchers and industry professionals to interact and share stories and research. This article aims to raise awareness of select annual opportunities and topics from the winter 2025 season.
Since 1966, Grey Bruce Farmers Week (GBFW) has kicked off the conference season in January. Co-ordinated by the team at Grey County Agricultural Services and primary producers, this week-long conference features a different topic of interest each day. This year, Dairy Day featured presentations on automation, ventilation in extreme weather conditions, herd longevity, a Dairy Farmers of Ontario update and succession planning. To provide a producer's perspective, the final session of the day featured a panel offering commentary on herd longevity, with farmers from across southwestern Ontario in attendance.
Eastern Dairy Days has been held over two days in St. Isidore and Kemptville in mid-February for almost 50 years. The conference aims to provide an opportunity for producers in eastern Ontario to meet, discuss the latest technology and pertinent issues, and interact and exchange ideas with other dairy professionals. In February 2025, topics included troubleshooting bacterial problems, beef on dairy calves, lessons from the U.S. experience with avian influenza and onfarm energy generation.
The Southwestern Ontario Dairy Symposium is an interactive event planned by producers for producers. The planning committee includes producer representatives from Essex-Kent, Lambton, Middlesex, Elgin, Huron, Perth, Oxford, Waterloo, Wellington, Brant, Norfolk, Wentworth, Haldimand and Niagara, in collaboration with the Ontario Ministry of Agriculture, Food and Agribusiness. The agenda is typically diverse and includes a producer panel. This year, topics included updates to the building code and a discussion around how farmers are already working toward sustainable solutions. Education extends into lunch with “Food from our Farms,” which provides an opportunity to showcase innovative products that are new or emerging on the market. Finally, a highlight each year is the networking that occurs before, during and after the conference.
This conference is organized by producers, researchers and industry representatives over three and a half days at the start of March in Red Deer, Alta. The Western Canadian Dairy Seminar offers a diverse range of opportunities and provides a chance to engage on topics such as herd longevity, dairy products, nutrition, reproduction, animal welfare and various other related subjects. Unique to this conference are the additions of a student poster and student presentation competitions. Students submit applications to present their research, and it is open to students with an interest in dairy research. This year, two University of Guelph students placed first in each of these competitions:
• 1st place presentation: Jessica Brasier;
• 1st place poster: Titouan Chapelain.
CDX is Canada’s largest yearly dairy showcase, featuring more than 350 exhibiting companies from around the world that bring the latest innovations to Stratford, Ont., in early April. This event includes several networking and educational opportunities. In 2025, the event included the Canadian Dairy Business Conference, CheeseFEST and Calves for a Cause sale.
Conferences provide a perfect opportunity for producers, researchers and industry professionals to interact and share stories and research.
This article is not intended to be an exhaustive list of all the learning opportunities available to the dairy industry, but rather to highlight the breadth and depth that is available. By keeping an eye on DFO Weekly Updates, Milk Producer magazine and other industry newsletters, producers can take advantage of ways to connect with experts and network with those in the industry.





















Get more insights into your dairy operation with the SenseHub® Dairy monitoring ecosystem
Gain the freedom and confi dence to make informed decisions with data and insights collected from individual animals on reproduction, health and milk quality monitoring. With SenseHub® Dairy, farmers can now incorporate a variety of features in their application plan:







SenseHub® Dairy Youngstock Help improve dairy calf performance by monitoring indicators of well-being, health and nutrition for the first 12 months of life.
SenseHub® Dairy In-Line MilkPlus Sensor* Monitor milk yield, fat, protein, lactose, blood and conductivity in real time to make informed management decisions for each individual cow.
SenseHub® Dairy In-Line Somatic Cell Count Sensor* Help improve milk quality and herd well-being with real-time somatic cell counts for individual cows at the milking point.

Scan to learn how to farm with more freedom.
*Additional hardware required This product is not intended to diagnose, treat, cure or prevent any disease in animals. For the diagnosis, treatment, cure or prevention of disease in animals, you should consult your veterinarian.
or
Financial literacy is a fundamental starting point for effective farm business management, helping producers understand the direct impact of their business decisions and opportunities available going forward.
Producers of all types and across all commodities will benefit from a deeper understanding of their financial situation and the options available to remain competitive and take calculated risks for continued success.
The program will be delivered virtually over the course of three two-hour sessions on Monday, May 5, Tuesday, May 6 and Thursday, May 8 from 1 p.m. to 3 p.m. EST.


Farm & Food Care Ontario (FFCO) will host the first Breakfast on the Farm (BOTF) event of 2025, hosted by Hoenhorst Farms and the Wensink family. On June 14, 2025, this fourthgeneration dairy farm near Innerkip will open its gates to welcome thousands of guests from Woodstock, London and surrounding areas.
Breakfast on the Farm events highlight the diversity of Ontario’s farming and food production, showcasing a variety of agricultural commodities, careers and opportunities. This June marks FFCO’s 25th BOTF event since the program’s inception in 2013. This June, guests will enjoy interactive displays and exhibits, get up close with livestock, explore farm equipment and have all their farming-related questions answered by farmers and industry experts.
To get involved and support this impactful outreach event, contact FFCO and help share the story of Ontario agriculture with a wider audience.
For more information, email info@farmfoodcare.org.






The Environmental Farm Plan (EFP) is an assessment voluntarily prepared by farm families to increase their environmental awareness in up to 23 areas on their farm. Through the EFP process, farmers highlight their farm’s environmental strengths, identify areas of environmental concern and set realistic action plans with timetables to improve environmental conditions. Farmers can then use their EFP in conjunction with cost-share programs to begin implementing their action plans.
The idea for EFPs originated from the Ontario farm community. Farmers were involved in every stage of developing the original EFP through the Ontario Farm Environmental Coalition (OFEC). The program continues to be delivered to the farm community by the Ontario Soil and Crop Improvement Association (OSCIA). OFEC was led by agricultural organizations including: Ontario Federation of Agriculture, Christian Farmers Federation of Ontario and Farm and Food Care Ontario.
OSCIA offers EFP workshops throughout the year. Below is the link to the workshop calendar and OSCIA is keen to offer workshops where there is interest. Contact your local field representative to discuss.
www.ontariosoilcrop.org/canada-ontario-environmental-farm-plan/ www.ontariosoilcrop.org/contact/.







Optimized Rations
Antimicrobial resistance (AMR) occurs when bacteria and other microbes become resistant to the drugs designed to kill them, making it harder to treat infections in cows (and humans). The Reimagining Resistance research project takes a unique, transdisciplinary approach to addressing this challenge, combining scientific research with perspectives from the humanities and social sciences to understand the complex factors driving antimicrobial use on dairy farms. We aim to develop practical, evidencebacked strategies that help farmers in their decisions around using antibiotics to maintain herd health.
Understanding antimicrobial use on dairy farms


Research Invitation to Dairy Farmers in BC and Ontario

Working with dairy farmers to support decisions about antibiotic use in dairy farming
Our goal is to find real, workable solutions that help farmers maintain herd health while using antimicrobials responsibly. This includes exploring alternative herd management strategies and strengthening collaboration across the dairy industry. It aims to create practical, sustainable solutions that protect both animal well-being and public health.
By working together, we can ensure a more sustainable, resilient future for dairy farming- protecting the well-being of animals, the livelihood of farmers, and the health of consumers. For more information, email lijunji@queensu.ca.

Take a 30 minute anonymous online survey Skip questions you don’t want to answer Participate in a research study that aims to understand how dairy farmers navigate their daily challenges and make decisions that impact their work and community life.
We are working directly with farmers, veterinarians, and industry experts to explore the farm practices and everyday realities that influence antimicrobial use. We seek to understand these complexities by surveying and interviewing farmers in two key dairy-producing regions of Canada: British Columbia’s Fraser Valley and Ontario’s Grey Bruce. Participants who complete the survey will receive a $20 honorarium for their time and will also be entered into a draw for one of several $100 dollar prizes. The project uses a One Health lens, which recognizes the interconnectedness of human, animal, and environmental health. It also takes a fresh look at microbes, considering their healthsupporting roles in dairy ecosystems.
– Save the date for June
26, when Forage Expo returns to Bruce County. Don’t miss your chance to see the latest forage equipment, watch field demos, attend the tradeshow and network with other producers. More details coming soon. Visit https://onforagenetwork.ca/ontarioforage-council/forage-expo/ for more

Hosted by Oceanbrae Farms, Belmont, PEI on Sat., July 19. All are welcome. RSVP to office@milkingshorthorn.ca.

‘‘ All future tankers I’m going to add to my fleet will be outfitted with this new suspension. ’’
Yvon Guérard Forfait Somerset, Plessisville, QC
BRITISH COLUMBIA
Mountain View Electric Ltd.
Enderby — 250 838-6455
Pacific Dairy Centre Ltd.
Chilliwack — 604 852-9020
ALBERTA
Dairy Lane Systems
Leduc: 780 986-5600
Blackfalds: 587 797-4521
Lethbridge: 587 787-4145
Lethbridge Dairy Mart Ltd.
Lethbridge — 888 329-6202
Red Deer — 403 406-7344
‘‘ Over rolling hills, even little bumps, it’s smooth working with a tanker fitted with the XT suspension. The tanker is independent from the tractor and its draw bar is no longer rigidly attached to the tractor. It is flexible and it actually follows the contour of the terrain. There’s a customer that we go to and there’s a 1-and-a-half-foot drop we need to drive through and there’s only one tanker that I will go there with, the one fitted with the XT suspension. ’’ Scan the QR code to hear the complete story.

SASKATCHEWAN
Dairy Lane Systems
Warman — 306 242-5850
Emerald Park — 306 721-6844
Swift Current — 306 203-3066
MANITOBA / NW ONTARIO
Penner Farm Services Ltd.
Blumenort — 204 326-3781
Thunder Bay ON – 800 461-9333
Tytech
Grande Pointe — 204 770-4898
ONTARIO
Claire Snoddon Farm Machinery
Sunderland — 705 357-3579
Conestogo Agri Systems Inc.
Drayton — 519 638-3022
1 800 461-3022
County Automation
Ameliasburg — 613 962-7474
Dairy Lane Systems
Komoka — 519 666-1404
Keith Siemon Farm Systems Ltd.
Walton — 519 345-2734
Lamers Silos Ltd.
Ingersoll — 519 485-4578
Lawrence’s Dairy Supply Inc.
Moose Creek — 613 538-2559
McCann Farm Automation Ltd.
Seeley’s Bay — 613 382-7411
Brockville — 613 926-2220
McLaren Works
Cobden — 613 646-2062
Melbourne Farm Automation
Melbourne — 519 289-5256
Watford — 519-876-2420
Silver-Tech Systems Inc.
Aylmer — 519 773-2740
Dunnville — 905 981-2350
ATLANTIC PROVINCES
Atlantic Dairy Tech.
Charlottetown, PE — 902 368-1719
Mactaquac Farm Equip. Ltd.
Mactaquac, NB — 506 363-2340
Sheehy Enterprises Ltd.
Shubenacadie, NS — 902 758-2002
Sussex Farm Supplies
Sussex, NB — 506 433-1699
Understanding our consumers is central to effective marketing; and staying connected with our consumers is key to ensuring we deliver messaging that will resonate with them –ultimately driving consumption. This is why consumer research plays such an integral role in guiding our marketing efforts.
Consumer research is crucial for shaping marketing strategies and ensuring campaigns meet consumer needs and expectations. It fosters connections with consumers and positively impacts communities. One such research study, our "Usage and Attitudes" survey, explored consumer behaviours around dairy products, including how consumers use milk. Findings from this research study gives us a comprehensive understanding of how people view dairy in their daily lives and how their attitudes may shift over time, allowing us to reach our consumers in a meaningful way.











Source: RMG. Usage and Attitudes Study. Ontario n=454. June 2022
Studies on dairy consumption and social media usage help refine marketing strategies, allowing for targeted and impactful messaging. Continuous surveys provide real-time data on consumer responses to campaigns. This constant flow of real-time data allows us to make quick adjustments to our campaigns and strategies, ensuring they remain relevant and effective.
Another way we use consumer research is in testing creative ideas with consumers during the development phases. This allows for feedback on various creative concepts and enables us to refine ideas to improve the effectiveness of our campaigns.
For example, before a new TV campaign is produced, we gather feedback from real consumers to validate the creative direction and ensure our messaging is clear. This process helps us fine-tune the message, tone and visuals, making sure when the campaign is produced, it’s poised to make the biggest impact. Additionally, once the TV campaign airs, we then post test the creative to ensure it is performing as we expected.






Likelihood to consume more dairy after watching +13%
Consumer research is the cornerstone of our marketing strategy, it ensures that our efforts remain focused on the people we serve. And, it helps us stay connected, relevant, and responsive to the needs of our consumers, while also honoring the values that drive us forward. As we continue to innovate and grow, we’ll remain committed to utilizing consumer insights to guide our marketing efforts, by doing so, we can ensure that our marketing not only resonates with today’s consumers but also supports a sustainable, vibrant dairy market in the years to come.

To meet the demand for milk in the Fall, the P5 Boards announced the following incentive days to be issued on a non-cumulative basis for the Fall of 2025: 1 day in September, 2 days in October, and 1 day in November.
The P5 provincial boards’ primary objective is to continuously monitor the milk market situation and meet demand in the most optimal way and will continue to adapt production signals to address market changes, as required.
When analyzing the markets, the national overall demand is currently tracking with the CDC optimistic scenario of 2.9 per cent. The national overall demand is tracking above the CDC optimistic scenario for the last four months available (October to January). Looking at the P5 quota, it is also tracking above the CDC’s optimistic scenario, at 2.8 per cent versus 2.6 per cent.
March25 Markets
P5 Message – 2025 Fall Incentive Days – conventional and organic
On the production side, butterfat production continues to be very strong, with a historical record high level butterfat test in raw milk. This situation results in less volume of milk in the system.
“This creates a situation where processors are requesting more milk to meet their skim milk needs and process the associated butterfat into butter. That additional butterfat ends up in the butter stocks. Typically, when demand is as strong as it is now, and a gap between the milk orders and milk supply is observed, butter stocks would normally decrease rather than increase, so what P5 is observing now is very unusual.”
Technical staff and CDC are currently investigating to better understand the situation. In the meantime, the national industry has agreed to not make any drastic decisions with the production signal sent to producers until things get clearer, and that another discussion takes place at the next national meeting in June. Therefore, there should be no additional production signal announcements until the June meeting.
To meet the demand for milk in the Fall, the P5 Boards announced the following incentive days to be issued on a non-cumulative basis for the Fall of 2025: 1 day in September, 2 days in October, and 1 day in November.
“P10 and P5 are filling their respective quota, which is on a butterfat basis, but the reduction in milk volume produced makes the protein market, for which the demand continues to grow, certainly tighter compared to recent years when the industry was dealing with significant surpluses” says Patrice Dubé, Dairy Farmers of Ontario’s chief economics and policy development officer.
The P5 provincial boards’ primary objective is to continuously monitor the milk market situation and meet demand in the most optimal way and will continue to adapt production signals to address market changes, as required.
The following table summarizes the incentive days:
The following table summarizes the incentive days:
As for the P10 over quota situation, recent numbers indicate that the P10 could be in an over quota situation as early as March 2025. Since the P10 over quota situation would be solely the responsibility of P5, a financial penalty could be imposed to P5 six months after, which means in September, unless P5 takes action to realign its production. However, in the context where there is a significant gap between milk orders and milk supply, it would be fair to expect that the national industry would decide in June to relax the national over quota calculation in such a way that P5 would not be penalized financially. The national meeting in June would also hopefully confirm the national industry players’ willingness to continue to meet the short- and longer-term market needs regardless of the national over quota situation.
In February 2025, butter stocks reached 39,129 tonnes, up from January by 2,834 tonnes. February butter stock levels are higher by close to 10,000 tonnes the five-year average level.
Cheese stock levels for the month of February 2025 were at 101,804 tonnes, up 418 tonnes from January and lower than the last five-year average but higher than 2023-24.
For the 52-weeks ending March 1, 2025, sales for fluid milk, fluid cream, yogurt, ice cream, cheese and butter increased/decreased by 0.4, 1.9, 4.8, 2.0, 2.0 and 4.3 per cent, respectively, compared with March 2024.
Canadian butterfat requirements in kilograms and actual butterfat production across the P10.
12-month requirements (in millions of kilograms) 12-month production (in millions of kilograms)
439.7 419.5
Canadian production has increased by 2.6 per cent over the previous 12 months, and requirements have increased by 2.5 per cent over the previous 12 months.
NATIONAL RETAIL SALES
Average increase in retail sales for dairy products sold in Ontario and the dairy product’s share of the total market sales, including at hotels, restaurants and institutions.
This graph shows Ontario’s SNF-BF ratio for the last 12 months.
As of March 26, 2022
* Source: AC Nielsen & StatsCan NOTE: There is a two-month lag in the national retail sales data.
• To meet the demand for milk in the Fall, the P5 Boards announced the following incentive days to be issued on a noncumulative basis for the Fall of 2025: 1 day in September, 2 days in October, and 1 day in November;
• On the production side, butterfat production continues to be very strong, with a historical record high level butterfat test in raw milk. This situation results in less volume of milk in the system;
• For the 52-weeks ending March 1, 2025, sales for fluid milk, fluid cream, yogurt, ice cream, cheese and butter increased/ decreased by 0.4, 1.9, 4.8, 2.0, 2.0 and 4.3 per cent, respectively, compared with March 2024.
Percentage of the total milk produced in Ontario that was used to produce dairy products.
February 2025
For February 2025 (kg of butterfat/kg of solids non-fat)
*There is a two-month lag reporting these figures
% Solids non-fat
Class 1a1 (includes Classes 1a2, 1a3, 1c and 1d for confidentiality reasons) Fluid milk and beverages
Class 1b Fluid creams Class 2a Yogurt, yogurt beverages, kefir and lassi
Class 2b4 (includes Classes 2b1, 2b2 and 2b3 for confidentiality reasons) Fresh dairy desserts, sour cream, milkshakes and sports nutrition drinks
Class 2b5 Ice cream and frozen yogurt
Class 3a1 Specialty cheese
Class 3a2 Cheese curds and fresh cheeses
Class 3b2 (includes Class 3b1 for confidentiality reasons) Cheddar cheese and aged cheddar
Class 3c1 Feta
Class 3c2 Asiago, Gouda, Havarti, Parmesan and Swiss
Class 3c4 (includes Classes 3c3 and 3c5 for confidentiality reasons) Brick, Colby, farmer’s, jack, Monterey jack, muenster, pizza cheese, pizza mozzarella and mozzarella other than what falls within 3d
Class 3c6 Paneer
Class 3d Mozzarella used strictly on fresh pizzas by establishments registered with the Canadian Dairy Commission
Class 4a Butter and powders
Class 4d (includes Classes 4b1, 4b2, 4c and 4m for confidentiality reasons) Concentrated milk for retail, losses and animal feed
Class 5a Cheese for further processing
Class 5b Non-cheese products for further processing
Class 5c Confectionery products
ONTARIO MONTHLY PRODUCER AVERAGE GROSS BLEND PRICE
ONTARIO DEDUCTIONS, PER HL
The graph below shows the 12-month blend price for the P5 provinces and Western Milk Pool (WMP).
*There is a two-month lag reporting these figures
$96
$94
$88 $90 $92
$86
A total 3,155 producers sold milk to DFO in February compared with 3,193 a year earlier. February 2025: $ 100.03 WMP: $91.84 P5: $92.02
$84
$82
QUOTA PRICES ($/KG)
For February 2025
* These figures are based on
The March 2025 Class III Price, US$18.62 per hundredweight, is equivalent to C$60.69 per hectolitre. This equivalent is based on the exchange rate US $1 = C$ 1.43589 the exchange rate when the USDA announced the Class III Price.
The Class III Price is in $ US per hundredweight at 3.5 per cent butterfat. One hundredweight equals 0.44 hectolitres. Canadian Class 5a and Class 5b prices track U.S. prices set by the U.S. Department of Agriculture.
Source: USDA
Co-ordinated by Dairy Farmers of Ontario’s communications and economics divisions. Questions? Please email questions@milk.org. STAY UP TO DATE!
Weekly Update email newsletter every Friday for Ontario dairy producers.
Milk Producer magazine is the voice of Ontario dairy producers. Subscribe for free or read online at www.milkproducer.ca.
Dairy Farmer Update provides updates with the monthly milk cheque.
Producer Dashboard , a secure platform behind your password on MMS that contains important news, updates and forms.
www.milk.org
Facebook: /OntarioDairy
Twitter: @OntarioDairy
Instagram: @OntarioDairy
LinkedIn: /company/Dairy-Farmers-of-Ontario
By Agricultural Communications and Epidemiological Research (ACER) Consulting; Émie Désilets and Annik L’Espérance, Dairy Farmers of Canada
FOR MORE THAN 25 YEARS, the NSERC Industrial Research Chair in Dairy Cattle Welfare at the University of British Columbia (UBC) has shaped how dairy cattle are cared for in Canada and beyond. With longstanding support from Dairy Farmers of Canada (DFC), researchers Dr. Dan Weary and Dr. Nina von Keyserlingk have led globally recognized work that has improved animal welfare, productivity and public trust in the dairy industry.
A new feature series: five fact sheets for practical on-farm application
To help farmers put this research into practice, DFC and ACER Consulting have developed a new series of five fact sheets. Each one summarizes key findings from UBC’s dairy welfare research in plain language and connects the science to everyday decision-making on the farm.
The topics include:
• Pain management for dairy calves;
• Feeding milk and colostrum to dairy calves;
• Social housing for dairy calves;
• Weaning strategies for dairy calves;
• Lameness and outdoor access in dairy cattle.
Each fact sheet highlights how research supports best practices and aligns with the requirements set out in the Code of Practice. Whether you’re reviewing calf feeding strategies or preparing to implement pair/ group housing, these resources are designed to support sound decisions grounded in science.
Why this series matters
This isn’t just academic work—it is research developed with farmers in mind. UBC’s animal welfare program has spent decades studying practical, real-world questions about how cattle experience pain, adapt to change and respond to different housing and feeding systems. With support from DFC, that work is now being translated into tools farmers can use today.
Canadian dairy farmers have always been leaders in animal care. These fact sheets are designed to support that leadership by offering clear, science-based guidance to help farmers meet evolving expectations and continue to provide excellent care to their animals.
Procedures like disbudding, dehorning and castration are a routine part of managing young dairy animals to improve safety, prevent injury and support long-term herd health—but they are painful. That’s why the Code

of Practice for the Care and Handling of Dairy Cattle and proAction® require the use of both a local anesthetic and a systemic anti-inflammatory drug, such as a nonsteroidal anti-inflammatory drug (NSAID), for these procedures. The research is clear: this two-step approach is the gold standard for effective pain control.
UBC researchers have shown calves receiving both a local anesthetic (like lidocaine) and an NSAID (like meloxicam) show fewer signs of pain, such as ear flicking, head shaking and licking at the wound. They also spend more time lying, indicating greater comfort. These findings come from years of work by Weary and von Keyserlingk and others, including studies that go beyond short-term pain to explore the lasting effects of painful procedures.
In one study, calves preferred to return to pens where they had received better pain control—evidence their experience influenced how they felt about the environment. Another study linked poor pain management to pessimistic behaviour in calves, a sign of negative emotional state. These findings show pain affects not only calf comfort, but also their mood, learning and behaviour after the fact.
For dairy farmers, this research reinforces a simple message: effective pain control improves animal well-being, supports recovery and is now an expected part of good dairy calf management.
To access the full fact sheet series, scan the QR code or visit DFC’s website at https://dairyfarmersofcanada. ca/en/dairy-research. For personalized advice, talk to your veterinarian or trusted adviser about how to apply these strategies on your farm.

The Canadian Podcow is a podcast hosted by dairy farmers, for dairy farmers. Hosts Andrew Campbell, a dairy farmer f rom Southern Ontario, and Sa rah Sache, a dairy farmer from B.C., tackle important topics that are relevant to dairy farming, including market analysis, outlooks, and trends.
In 2024, the Canadian Podcow was selected amongst the Top 15 Canadian Agriculture Podcasts by Feedspot!
The French-language counterpart, Entre deux traites, delves into the same topics for a Francophone audience. Host and dairy producer Alain Lemieux brings a lively perspective to conversations with a wide range of guests from across the sector.
Listen to the latest episodes of the Canadian Podcow for a deep dive into the topics and presentations from DFC’s 2025 Annual Dairy Policy Conference (ADPC)!
The hosts were live on l ocation at the ADPC in Ottawa, holding in-depth interviewsand insightful conversations with presenters on the hot topics of today.
Listen to the Secretary General of the European Dairy Association, Alexander Anton, spea k on dairy from a Eu ropean perspective; DFC Chief Marketing and Communications Officer Pamela Nalewajek talk about how “buying Canadian” can positively impact dairy; and DFC’s Julia Trottier and Maxime Collette provide an outlook on the dairy market for 2025.







By Veal Farmers of Ontario
FEEDING CALVES MILK IS FUNDAMENTAL TO THEIR GROWTH AND HEALTH. This article explores the benefits of feeding cold acidified milk, providing a practical solution for optimizing feeding practices.
To acidify milk or milk replacer, follow a protocol developed with your nutritionist or herd veterinarian to add acids (like formic or citric) and





lower the pH. When done correctly, acidified milk will be suitable for room temperature storage, with a pH ranging from 4.0 to 4.5, which helps keep bacterial growth in check.
Benefits of feeding acidified milk
1. Bacterial control: Acidifying milk inhibits harmful bacteria, such as E. coli, Salmonella, and Staphylococcus, reducing infection risks and improving calf health;
2. Extended storage: Acidified milk can be stored at room temperature for up to three days without significant bacterial growth, which is beneficial in group housing systems where milk is provided ad libitum;
3. Improved digestive health: Acidified milk contributes to better fecal consistency and reduced scours (diarrhea) in calves, due to a more stable pH environment in the digestive tract;
4. Ease of management: Feeding acidified milk simplifies the process since it does not require heating, saving time and reducing labour costs;
5. Calf adaptation: Calves can adapt to drinking cold milk without adverse effects. Studies show no significant differences in growth or health between calves fed cold milk and those fed warm milk if the milk is consistently available.
Cold acidified milk slows the rate at which milk exits the abomasum and enters the small intestine, aiding nutrient absorption. This slower passage allows the digestive system more time to process nutrients, enhancing calf health.



of all types of milking parlor frames
Parabone
Herringbone • Parallel
Rapid Exit
Tandem style
Also custom orders • Self lock head gates
Pro free stalls
Slant stalls and gates
Calf pens
Tie stalls
Tip tanks
Utilizing insulated containers or specialized feeding systems is an effective strategy to maintain milk at a stable temperature, regardless of weather conditions. In both hot and cold climates, insulated containers help ensure the milk remains at an optimal temperature, preventing it from freezing in cold weather or spoiling in hot weather.
By keeping milk at a consistent temperature, insulated containers not only enhance the safety and quality of the milk but also contribute to the calves’ overall health and well-being. This approach simplifies the feeding process and ensures calves receive milk that is both safe and nutritious, regardless of external temperature fluctuations.
In colder climates, monitor milk temperature to prevent freezing. Extremely low temperatures can make it difficult for calves to drink and may lead to hypothermia. Regularly check milk temperature and quality to ensure it remains safe for consumption.
To implement an acidified milk feeding program, focus on equipment, consistency and monitoring. Use well-maintained equipment, maintain a consistent feeding schedule and regularly monitor calf health. These practices support the calves’ overall well-being.
Feeding calves acidified milk can be beneficial for managing calf health and nutrition, especially in group housing systems. It controls bacterial growth and extends milk’s storage life, improving calf health and reducing digestive issues. Proper preparation methods and potential risks should be considered to ensure the best outcomes for calf rearing.

For more detailed information and resources visit CalfCare.ca. Calf Care Corner, brought to you by Veal Farmers of Ontario, delivers the latest information to help you improve the way calves are raised on your farm. Follow @ CalfCareCorner on Facebook and sign-up for monthly e-newsletters on calfcare.ca.

•
•
•


By Chris McCullough
HAVING SPENT MOST OF HIS TIME TRAVELLING THE WORLD SHEARING SHEEP, United Kingdom-born Will Hinton has changed farming direction and is now milking cows on a share farming basis in New Zealand.
Together with his partner Kali Rangiawha, the couple run K&W Hinton Farms, the name of their business formed over four years ago.
Will hails from Wiltshire, England, where he grew up following the sheep shearing trail before travelling down under to perfect his craft. It was while on this quest in 2017 he met New Zealander Kali, who had accrued a wealth of dairy experience, and before long kids were born and roots settled.
For the past 17 months, the couple have been contract milking 350 cows on a 280-acre farm located near Fielding, in the Manawatu district on the North Island.
Will and Kali have three children: six-year-old Rylan, three-year-old Billy, and one-year-old Blake. In 2024, the couple won the New Zealand share-farmer of the year award.
“With several years of dairy experience, Kali was the key driver behind our contract milking business we started four years ago,” Will says. “The farm we are on now is owned by Tim and Victoria Gorton. This is their first year owning a dairy farm, so they have employed us to run it for them, whilst leaning on us for our experience.”
Will adds they milk 350 crossbred cows twice daily through a Waikato milking system 54-unit rotary parlour. “Milking takes 1.5 hours in the morning and one hour in the afternoon. This past year, we achieved a record production for the farm of 443 kilograms milk solids per cow,” he says.
Kali also works as an AI technician for LIC, an agri-tech and herd improvement co-operative, and likes to run a tight spring calving system to match grass growth on the farm.
“Compact calving is very popular over here, run to match grass growth,” she says. “We calve the cows from mid-July through to the end of September, with the majority calving in the first six weeks.
“Three major breeding traits we are concentrating on include breeding worth, the genetic potential for profitable offspring and feed efficiency.
“Also, production worth (PW), which is the cow’s lifelong profit-making ability. Our top PW cows receive sexed semen and the bottom tier receive beef semen.
“And lastly, lactation worth, which reflects how profitable and efficient a cow has been within the current lactation.”
Will and Kali run the cows as a single herd grazing outdoors all year long. The mating season is kept at around 10 weeks, six weeks for AI and four weeks using a bull.
Operating a share-farming model means costs have to be monitored carefully, including labour use.
“We run the farm ourselves but this season we are employing someone so we can start training them up before we take our next step up in the industry of owning a herd,” Will says. “Our milk goes to Open Country and the price is around $8.40 per kilogram of milk solids. We receive just under 20 per cent of the milk income but have to pay fuel, power, labour, etc.”
Will achieves 14 tonnes of grass per hectare, a total of 1,580 tonnes dry matter, which accounts for 81 per cent of the cows’ diet. He also feeds a straight palm kernel expeller blend through the shed’s feeding system and uses 100 tonnes of maize as a transitioning tool in early spring, and as a condition builder in late lactation.

“Our go-to for quality, comfort, peace of mind.”


and Amanda (Brandon) Milking 64 Registered Holsteins, 11,700 kg M, F 410 kg, P 355 kg, 11 EX, 26 VG



We have been using Udder Comfort™ for over 20 years. At Brookturn Farms, we believe in being proactive not reactive. We use Udder Comfort on our fresh cows to ensure our cows are off to a great start to set the stage for a successful lactation. By using Udder Comfort, we are able to prevent problems and keep the milk owing into our bulk tank!



We believe our cows are like professional athletes – Brookturn Dempsey Pleasant EX-94 4E* Lifetime Production (6 lactations): 82508 KG3.9%F 3.4%P the perfect example! The kind of cow that will get any Dairyman excited! By putting cow comfort rst and using Udder Comfort it has been a contributing factor to sustaining great udder health. We breed for the kind of cow the lasts and improves our bottom line with ease and she does just that!
Scan QR or go to link to read more about Brookturn https://wp.me/pb1wH7-k8


“Our target has now changed to around 600 cows, which we hope to purchase this year. In the next five years, we would like to increase this to 1,000 cows and own a farm by 2034.”
– Will Hinton
“We also grow summer crops, such as chicory, to complement the drop in metabolizable energy (ME) and crude protein (CP) in pasture, which helps us hold production levels,” he says, adding he is passionate about feeding and the transition phase and thinks they are crucial. “It is challenging here (since) pasture is a huge part of the cows’ diet and therefore it is hard to achieve a low dietary cation-anion difference (DCAD).” DCAD is a particularly important measure used when formulating diets for dry, transition and lactating dairy cows. “In the future, I’d like some technology that tells me how well each cow is transitioning (since) it would let me pick up subclinical cows a lot quicker.”





The couple’s five-year goal is to own 200 cows, a target that could have been reached this year, but was pushed forward to ensure a good work-life balance with raising three young children.
“Our target has now changed to around 600 cows, which we hope to purchase this year. In the next five years, we would like to increase this to 1,000 cows and own a farm by 2034. It was amazing that we won the national share-farmers of the year award, which is the top tier of the New Zealand dairy awards. This is a lifetime achievement for us and will definitely help us with some amazing opportunities going forward,” Will says.
Looking into the future, Will knows there will be some tough challenges ahead. “I think the progression ladder is getting a lot harder in New Zealand. Farm ownership used to have a clear trajectory but with inflation of farm working expenses, high interest rates and average milk prices, these all seem to be moving the goal posts further away.
“I think global environmental regulations will be more challenging, but I feel this is an exciting challenge. We need to reduce our carbon footprint per kilogram of milk solids.
“We are at the forefront of the lowest carbon footprint per litre of milk in the world, but we need to maintain this. By improving the bottom 25 per cent of our herds and breeding more resilient cows, we can then slowly reduce our stocking rate,” he says.
























The MagStream™ milk meter is wirelessly streaming data as it provides a 100% free flow of the milk stream. For maximum efficiency, the meter accurately monitors the milk flow and milking process to smartly automate cluster take-off, adaptive pulsation, stimulation and more. And the meter ensures a continuous and completely free milk and air flow, making vacuum drops and fluctuation caused by milk meters a thing of the past. Cows are milked Gently, Quickly and Completely™, improving milk quality - and the life of your dairy. Leran more aobut this ICAR freelow meter at


“Now we’re proactive instead of reactive with Excel Calf.”

• To give newborn calves a confirmed supply of trace minerals.
• Helps build immunity, will boost growth rates, and is a highly available source of trace minerals to these monogastric animals.

• Newborn calves start with 5 ml/head/day & increase as the calf grows.
• This product is usually added to the milk but can be top dressed on to dry feed.